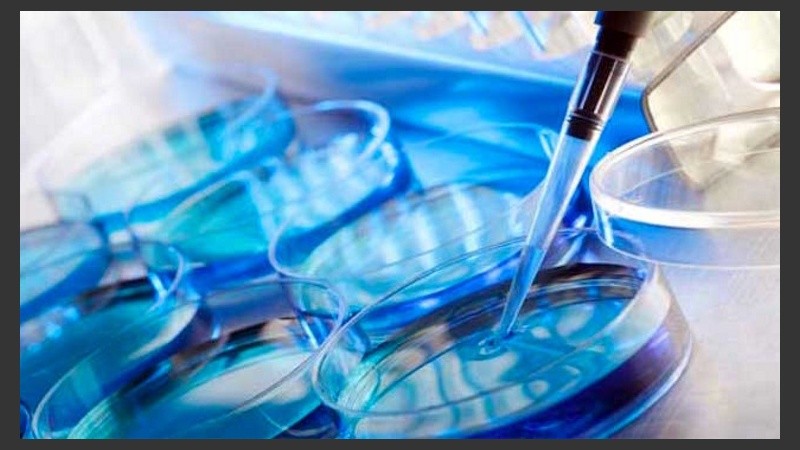
Hasta la fecha, han ocurrido en el mundo más de 5 millones de nacimientos por Técnicas de  Reproducción Asistida.

Desde el nacimiento de Louise Brown, en el Reino Unido el 25 de julio de 1978, hasta la fecha, han ocurrido en el mundo más de 5 millones de nacimientos por Técnicas d. Reproducción Asistida. Esto ha permitido estudiar y conocer la evolución de estos embarazos y de los niños nacidos, por estas técnicas, Rosario 3 consultó con el doctor Diego C. Iglesias, médico especialista en Tocoginecología, quien analiza esta evolución:
“En nuestra ciudad, el primer embarazo por Fertilización In Vitro (FIV) se obtuvo en 1986, por el trabajo de los doctores Carlos Morente, Pedro R. Figueroa Casas y Alberto Badano; desde ese momento a esta parte, el número de casos ha crecido en forma sostenida, pero desde el advenimiento en nuestro país de la Ley de Asistencia Reproductiva (2013), el acceso a estos tratamientos, está disponible para un porcentaje mucho mayor de la población; en nuestro Centro, durante el año 2015, se han realizado cerca de 1000 procedimientos de Alta Complejidad (FIV- ICSI), con tasas de embarazo clínico cercanas al 40%”.
¿Los embarazos obtenidos por las técnicas de reproducción asistida difieren de aquellos embarazos logrados sin recurrir a ellas?
“Los embarazos obtenidos por estas técnicas presentan algunos riesgos adicionales, si los comparamos con embarazos obtenidos en forma espontánea. Entre estos riesgos podemos mencionar el aborto espontáneo, el parto prematuro, la hipertensión y pre eclampsia, la diabetes gestacional, las hemorragias durante el embarazo y postparto, la incidencia de cesáreas, los niños con bajo peso al nacer, el ingreso a Neonatología, etc.
Estos riesgos, si bien deben ser tenidos en cuenta por los pacientes y los profesionales al momento de decidir qué camino seguir en el tratamiento, no están relacionados directamente a las técnicas de Reproducción Asistida, sino a otras variables como: el tiempo de infertilidad, la edad de las pacientes, la obesidad, la presencia de enfermedades concomitantes (ginecológicas o de otros sistemas); y, sobretodo, el embarazo múltiple, cuestiones que juegan un papel preponderante en la frecuencia de las complicaciones antes mencionadas”.
¿Los embarazos múltiples se dan con mayor frecuencia?
“El Embarazo Múltiple es la variable más importante que relaciona a estas técnicas con complicaciones durante el embarazo y el puerperio, para las madres y sus hijos. En los últimos años, se han instaurado estrategias para disminuir los embarazos múltiples. La Transferencia de un Embrión Único (TEU), ha logrado disminuir en forma drástica la frecuencia de estos embarazos y sus complicaciones”.
¿Cuál es el principal objetivo que persiguen los médicos especialistas en Medicina Reproductiva?
“El principal objetivo de los médicos que nos dedicamos a la atención de parejas con dificultades para obtener un embarazo y su seguimiento, es que éste transcurra con las menores complicaciones posibles para la madre y el niño. Es importante insistir: la mayoría de estos embarazos transcurren sin problemas.
La consulta rápida de la pareja con dificultades para concebir, el tratamiento racional y el seguimiento adecuado, permiten disminuir en gran medida las complicaciones posibles y lograr el resultado esperado”, concluye Iglesias.